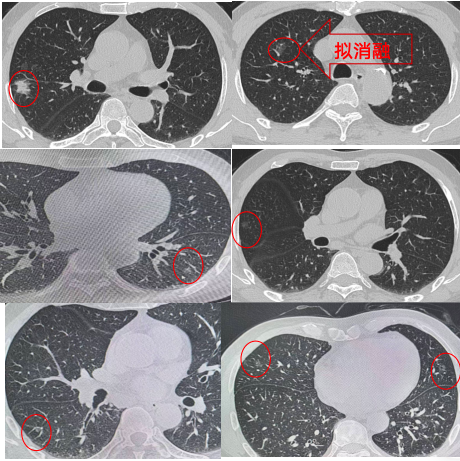
from clipboard

职位推荐
- 珍格医疗-临床销售 15001-20000
- 地奥制药-医药代表 6001-8000
- 普利德医疗-医疗设备销售经理 面议
- 大唐-兼职招商经理 面议
- 景德中药-直营经理 6001-8000
- 安邦医药-省区招商经理 8001-10000
- 恒瑞医药-医药信息沟通专员 6001-8000
- 黄河中药-学术讲师 8001-10000
发布日期:2024-09-20 浏览次数:260
近日,我院胸外科刘伦旭教授、蒲强教授、廖虎副教授团队成功为一名患有双侧多发肺结节老年患者实施“杂交”手术。该手术结合了射频消融和胸腔镜下微创手术两种术式,一次性解决了患者肺部的多发“高危”结节,同时最大限度地保留了肺功能,术后患者生命体征恢复平稳,术后2天即出院。经过文献检索,这也是我国西部地区首例射频消融和胸腔镜下微创“杂交”手术。
患者杨先生68岁,2月前因咳嗽于当地医院就诊行胸部CT检查发现双肺多发结节,最大者位于右肺上叶后段,大小约2.3cm*1.7cm,所有结节临床评估均考虑为早癌或癌前病变。
围绕患者病情,团队开展了全科讨论:患者右肺多发结节,部分肺结节的位置较深,若按照传统外科手术方法需要进行右肺上叶+中叶切除+右肺下叶部分切除,还需要对患者左肺的结节也进行二期手术。然而患者既往存在有多种合并症,如中-重度阻塞性通气功能障碍等,肺功能较差,同时进行多个肺叶切除,其肺功能将无法耐受,对侧的结节也将丧失手术的机会。
患者病情特殊,考验着胸外科医生术前手术方案的设计、术中手术操作,以及术后监护管理。刘伦旭教授、蒲强教授、廖虎副教授团队决定尝试采用一种创新的“杂交”手术,即对危险性较低的磨玻璃结节,选择行射频消融,以减少对患者的创伤;而对右肺上叶后段较大的、危险性更大的结节,选择胸腔镜微创手术切除右肺上叶后段肺组织。
团队与患者及家属进行了充分沟通,并进行了扎实的术前准备,包括穿刺方案,消融方案,及术中可能遇到的并发症及应对措施,以及术后并发症的预防和处置方案等。8月15日,手术按计划进行。患者全麻后,廖虎副教授首先根据移动CT扫描引导下行经皮消融针穿刺,穿刺成功后行射频消融治疗。随后,立刻改变体位为患者行单孔荧光胸腔镜右肺上叶后段切除+右肺中叶楔形切除+右肺下叶楔形切除。术后经过观察,无特殊不适,安全返回病房。术后第一天复查胸片无特殊,术后第2天引流较少,即安排拔管出院,由于保留了足够的肺组织,患者术后运动耐量良好,经初步评估可耐受对侧手术。

随着人们健康意识的增强及低剂量胸部CT筛查的普及,越来越多的肺结节被发现,其中肺多发结节的处理一直是困扰着患者和医生的难题,国际及国内的专家共识都主张在最大限量保留患者肺功能的前提下,尽量处理更多的高危结节。体积较大、恶性程度高的结节通过微创手术切除;体积较小、恶性程度低、位置较深导致切除范围大的结节通过介入消融治疗的策略,得到越来越多的医生及患者的认可。全身麻醉胸腔镜微创手术的同时行肺结节消融术,将两种术式联合进行,一次性完成多发肺结节的诊断和治疗,有效减少手术创伤,完美解决患者肺功能无法耐受双侧肺手术的问题。本次胸外科完成“杂交”手术,充分展现了华西医院胸外科的巨大技术优势和以人为本的治疗理念。
300多万优质简历
17年行业积淀
2万多家合作名企业

微信扫一扫 使用小程序

